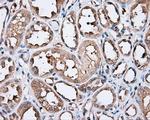
PIM2 Antibody in Immunohistochemistry (Paraffin) (IHC (P))

Search
OriGene
PIM2 Monoclonal Antibody (OTI5D5), TrueMAB™
{{$productOrderCtrl.translations['antibody.pdp.commerceCard.promotion.promotions']}}
{{$productOrderCtrl.translations['antibody.pdp.commerceCard.promotion.viewpromo']}}
{{$productOrderCtrl.translations['antibody.pdp.commerceCard.promotion.promocode']}}: {{promo.promoCode}} {{promo.promoTitle}} {{promo.promoDescription}}. {{$productOrderCtrl.translations['antibody.pdp.commerceCard.promotion.learnmore']}}
产品信息
CF501063
种属反应
宿主/亚型
分类
类型
克隆号
抗原
偶联物
形式
浓度
纯化类型
保存液
内含物
保存条件
运输条件
产品详细信息
For reconstitution, we recommend adding 100 µL distilled water to a final antibody concentration of about 1 mg/mL. To use this carrier-free antibody for conjugation experiments, we strongly recommend performing another round of desalting. (Zeba Spin Desalting Columns, 7KMWCO, 0.5 mL, Product # 89882)
靶标信息
PIM2 is a proto-oncogene which phosphorylates BAD, which partially inhibits its apopotopic function. PIM proteins (PIM-1, PIM-2 and PIM-3) are oncogene-encoded serine/threonine kinases. PIM-2 is highly homologous to Pim-1 with similar oncogenic functions. PIM-2 is most abundantly expressed in hematopoietic tissues, spleen, thymus, and peripheral blood leukocytes, as well as in testis, small intestine, and colon. PIM2 expression is negatively regulated by growth factor depletion. Increased levels of PIM-2 has also been observed in certain cancers.
仅用于科研。不用于诊断过程。未经明确授权不得转售。
篇参考文献 (0)
生物信息学
蛋白别名: pim-2 oncogene; Pim-2h; proto-oncogene Pim-2 (serine threonine kinase); serine/threonine protein kinase pim-2; Serine/threonine-protein kinase pim-2
基因别名: PIM2
UniProt ID: (Human) Q9P1W9
Entrez Gene ID: (Human) 11040